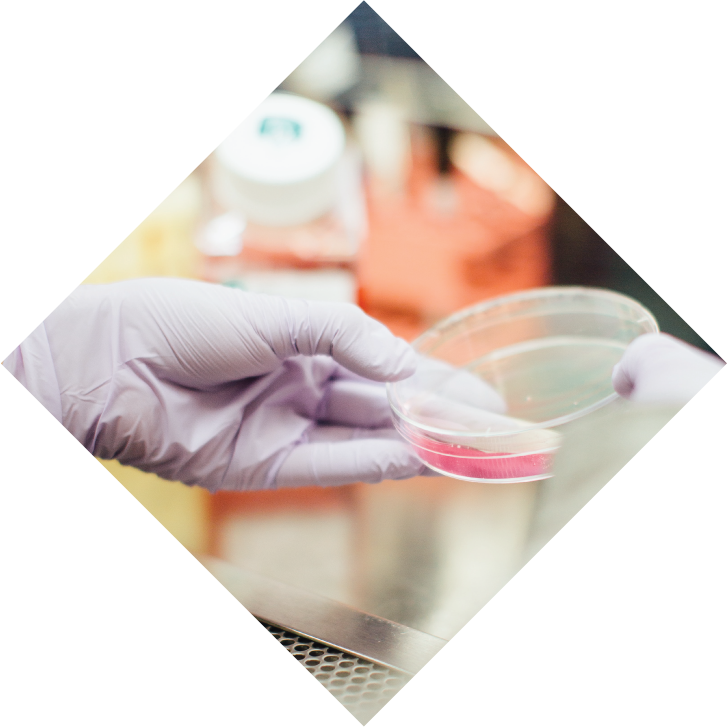
Image

The Autism Discovery and Treatment Foundation
The Autism Discovery and Treatment Foundation (ADTF) is a 501c organization dedicated to solving complex medical problems. The overall aim of ADTF is to improve the lives of individuals and families living with chronic diseases which have been difficult to treat and/or cure. Our focus is on autism and other neurodevelopmental disorders.

Background
It's time to understand autism.
Autism is a complex behaviorally defined neurodevelopmental disorder that affects one out of every 52 children born in the United States. There are no known causes for autism; therefore, no known measures that can be taken to prevent spectrum disorders. Autism knows no racial, ethnic, or social boundaries and can affect any family and any child.
We believe that many opportunities and answers lay ahead. Autism Discovery & Treatment Foundation is now ready to conquer new endeavors that will have lasting impact on the lives of children with autism and their families.
Our Goal
It's time to move the ball forward.
Researchers have already discovered several abnormalities in cellular metabolism that are more frequent in children with autism than in their typical peers.
Tests have been developed to look at these differences, which are referred to as biomarkers. We know there are many more biomarkers waiting to be discovered.
Once a biomarker is discovered, we can work to develop treatments or interventions that “normalize” the functioning of the cell or the metabolism and ensure that the treatment works in individual children by repeatedly measuring these biomarkers.
We have observed improvements in some children who received specific treatments based on the type of abnormality or biomarker that they had. Our goal is to further study these biomarkers and potential treatments and improve the standard medical practices around Autism.

Our Approach
Going Big by Going Small: A Biochemical Approach.
We aim to improve the accuracy of diagnosis and the effectiveness of treatment by identifying treatable biologically valid mechanism and causes of disease, then developing and validating practical and safe treatments.
We are searching for predictive biomarkers of autism that may facilitate early diagnosis and provide a treatment target to arrest and possibly prevent the development of autism in susceptible children.
Another component of our mission is to educate the scientists, medical professionals and general public regarding new developments in biological mechanisms and treatments.
We are searching for predictive biomarkers of autism that may facilitate early diagnosis and provide a treatment target to arrest and possibly prevent the development of autism in susceptible children.
How We Work
Putting the Pieces Together.
We are ready to advance our collective understanding of Autism by investing in research for Biomarkers and Treatments. We want to build a process that moves promising ideas from basic research to clinical products that improve lives.
Diagnostics
Diagnostics
Fund projects that develop diagnostics and preclinical assays to assess biomarkers for neurodevelopmental disorders.
Research
Research
Fund basic and translational research that identifies biomarkers.
Treatments
Treatments
Offer safe and effective treatments for patients with neurodevelopmental disorders.
Clinical Trials
Clinical Trials
Fund clinical trials aimed at FDA approval.
Leadership Team
Doctors and Scientist Ready to Connect the Pieces.
The Autism Discovery and Treatment Foundation was created by physicians dedicated to advancing our understanding of complex neurodevelopmental conditions. The talent exhibited by our team provides the ability to handle great challenges. It is easy to see that their work has much meaning to them and those they serve.
Dr. Richard Frye, MD, PhD
Dr. Daniel Rossignol, MD FAAFP
Foundation Projections
Funding Project that Change Lives
Year 1
$400K in Donations
Year 1
Year 2
$1M in Donations
Year 3
$6M in Donations
Year 3
Year 4
$8M in Donations
Year 5
$10M in Donations
Year 5
Building on Decades of Research
Read our published case studies, clinical trials, and other research
Improving Lives"Today, autism is shrouded with mystery. We don’t know its causes; thus, we don’t know how to best treat a child with autism or how to prevent autism from occurring. Only through research, in both laboratory studies and in clinical trials, can we make discoveries that will lead us to treatments or prevention strategies. Our foundation will bridge the gap between clinicians and laboratory scientists, often referred to as translational research, and will foster a dynamic flow of ideas in which knowledge will be turned into medical practice."
Dr. Richard Frye, MD, PhD
Founder of ADTF
"Today, autism is shrouded with mystery. We don’t know its causes; thus, we don’t know how to best treat a child with autism or how to prevent autism from occurring. Only through research, in both laboratory studies and in clinical trials, can we make discoveries that will lead us to treatments or prevention strategies. Our foundation will bridge the gap between clinicians and laboratory scientists, often referred to as translational research, and will foster a dynamic flow of ideas in which knowledge will be turned into medical practice."
Dr. Richard Frye, MD, PhD
Founder of ADTF
Contact Us
If you are interested in supporting our foundation, we would love to hear from you! We welcome donations to fund our critical research as well as inquiries and collaborations with our medical and scientific peers.







